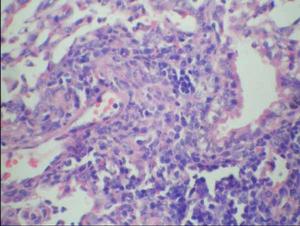
王良
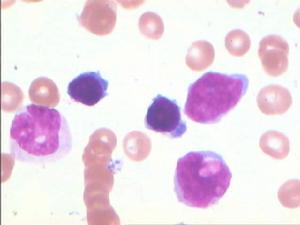
王良

人物簡歷
1891年5月5日出生於四川成都。
1913年畢業於安南(今越南)河內醫學院,同年返回成都任平安橋醫院醫師。
1915年任重慶仁愛堂醫院醫師。
1931―1933年赴法國巴斯德研究所學習。
1933年從法國帶回卡介苗菌種及儀器設備,在重慶自設的微生物實驗室,培養製造卡介苗,繼而在國內開始對嬰幼兒進行接種。
1951年組建西南卡介苗製造研究所並任所長。
1956年西南卡介苗製造研究所併入成都生物製品研究所,王良任副所長兼卡介苗室主任。
1956―1985年王良被選為第三屆全國人大代表,第四屆、第五屆全國政協委員。
1985年8月31日病故於成都,終年94歲。
生平概況
 四川成都
四川成都1925年,他得知法國科學家發明的卡介苗能有效地預防結核病,遂計畫到法國巴黎巴斯德研究所學習製造卡介苗。不料在他籌資出國之際,德國呂伯克城發生了卡介苗接種事故,240名口服卡介苗的兒童中有72人喪生。這一事件震驚了全世界,使卡介苗的發明人之一卡爾梅特,因驚恐成疾,同時,也使王良大失所望。後經德國政府組織一專家小組調查,查明事件系在製造菌苗過程中,技術人員將卡介苗與一種名為Keil的毒株放置在同一溫箱中培養,使卡介苗受到污染所致。從而消除了許多人對卡介苗的懷疑,也堅定了王良赴法學習、研究卡介苗之決心。
1931年,王良由重慶出發赴滬,乘法國郵輪去巴黎,行抵印度洋時,郵輪不慎失火,幸獲救得免葬身魚腹。王良抵巴黎後,即進入巴斯德研究所卡介苗室學習。當時卡爾梅特因呂伯克城事件抱病在身,卡介苗的生產、研究及培養學習人員事務,概由卡介苗的發明人之一介蘭負責,王良親受其傳授、指導。王良首先用巴黎菌種自己培養製造的卡介苗免疫了豚鼠,經長時間觀察,動物安全無恙,證明卡介苗是安全可靠的。他在巴黎學習期間共完成四篇論文,前三篇是關於卡介菌和結核菌的培養的,研究如何促進卡介菌生長發育的。後一篇是關於霍亂菌的培養及如何製造霍亂菌苗的。
1933年夏,王良購置了一些實驗設備帶回國,以充實國內自設的實驗室。
 嬰幼兒
嬰幼兒正當王良擬進一步推廣卡介苗接種時,抗日戰爭爆發了。1939年國民政府衛生署從武漢遷來重慶。該署派員到王良的實驗室查看後,立即下令停止製造和接種卡介苗,這一強制行為深使王良痛心。他曾回憶說:“我用盡了所有力量和心血,原以為可以為防癆事業盡一份微力,以提高人民的健康水平,不料20年的心愿竟成泡影。”儘管如此,他仍按卡爾梅特和介蘭所授之法繼續保存了所帶回國的卡介苗菌種。
1949年11月,中國人民解放軍進駐重慶,不久西南軍政委員會衛生部成立了。錢信忠部長親自到王良實驗室參觀,備加慰勉,並邀王良參加1950年第一屆全國衛生會議。會議期間,王良受命籌建重慶西南卡介苗製造研究所,並任所長。從此他精神振奮,工作熱情高漲。他親自參加卡介苗培養製造工作,重慶夏季炎熱,此項工作也從未間斷。
1956年,西南卡介苗製造研究所併入成都生物製品研究所,王良任副所長兼卡介苗室主任。同時,還成立了王良研究室,從此他以更大的熱情投身於卡介苗及免疫機制的研究工作之中。
1、提高卡介苗質量的試驗研究
卡介苗
卡介苗計數方法無疑也是影響活菌數的原因之一。王良認為耗氧量測定法較為迅速及時,但往往不易與菌落計數法相吻合。為了使兩者結果接近,王良設計了一些試驗方法和統計學處理方法,使操作者稱便。
在卡介苗延長效期方面,王良經對生產的10批卡介苗進行了觀察,提出了實驗數據,證實冰櫃保存6周的菌苗,仍有26%的活菌。例如,一批液體卡介苗每毫克中有1600萬個活菌,6周后,每毫克中仍有400萬個,這個數量的活菌數,足以引起免疫力。
2、選擇卡介苗菌種的研究
 小白鼠試驗
小白鼠試驗3、卡介苗所含酶的探討
王良對免疫動物的酶,特別是肝臟脂酶的活力進行了研究。他發現卡介苗免疫後,小鼠肝臟脂酶活力加強,它雖非抵抗結核菌的唯一原因,但也是重要因素。機體缺乏脂酶的分解、綜合作用,細胞則缺乏清除細菌的能力。值得注意的是結核菌感染後,動物分解脂酶的能力大大降低。能否從測驗酶的種類及其活力來分別不同菌株,還有待進一步研究,或許它對酶的探討,對結核免疫學及診斷學有一定意義,亦未可知。
4、卡介苗免疫機制的探討
淋巴細胞
淋巴細胞現代結核免疫學認為,結核病免疫主要是細胞免疫,體液抗體不起主要作用,並認為變態反應及細胞免疫同時存在,但是這個觀點還遠未能統一,直至最近還有報告B細胞同樣能釋放移動抑制因子(MIF)。在王良研究課題中,從未把細胞免疫和體液免疫截然分開。例如他多次注意到免疫動物血液中各種免疫球蛋白明顯增加,並當動物變態反應消失時,保護力在一定時間內依然存在。
事實上,卡介苗不僅能刺激細胞免疫,也能激發體液抗體,這從王良首次接種嬰幼兒所見到的非特異性免疫已可證實。他在對卡介苗接種後對傷寒菌、鏈球菌、葡萄狀球菌的抵抗力的研究中觀察到,卡介苗接種後對上述各菌的抵抗力明顯提高,小鼠免疫後14天,用4―10倍半數致死量的傷寒菌攻擊,結果對照組有90.4%的小鼠死亡,而免疫組僅有27.2%的小鼠死亡。他又觀察到用卡介苗免疫之家兔血液中,鏈球菌消失很快,而對照組的家兔血液中鏈球菌則明顯增加。
王良從青年起,即立志於防癆事業,中華人民共和國成立後,更以高度熱情從事卡介苗製造研究工作。他對研究工作的態度非常嚴謹,多數是親自操作,對助手試驗結果往往要親自核對並詳細記錄。他為人謙虛謹慎、平易近人,注意培養接班人,年近90高齡時,還親自編寫講義為青年們講課。
1981年,四川電視台根據一篇科普文章《防癆武器卡介苗》編導了一部以王良生平為背景的電視片。
 中華醫學會
中華醫學會1985年8月31日,王良病逝於成都,終年94歲。
主要論著
1王良.結核菌現時的分離法及培養.醫藥評論,1933,5(5):20―24.
2王良.BCG之培養及製造.醫藥評論,1934,6(3):13―16.
3王良.一種配製便利的淋菌培養基.醫藥評論,1935,7(2):33―35.
4王良.鑑別霍亂菌之幾點.醫藥評論,1935,7(7):5―6.
5王良.重慶BCG(卡介苗)自行接種嬰兒之概況,中華醫學雜誌,1935,31(11):1209―1212.
6王良,王覺民.精製結核菌素試驗工作報告.1958.
7王良,鄒邦柱,朱滋英等.不同來源六株卡介苗株生物學性狀及免疫性比較研究初步報告.衛生部生物製品檢定所學術論文集,1958:46―58.
8衛生部成都生物製品研究所第四研究室卡介苗組.卡介苗與耐異煙肼卡介苗免疫力及治療結核病效果的研究.衛生部成都生物製品研究所科研資料.1960.
9衛生部成都製品研究所第四研究室.卡介苗免疫機制的研究.衛生部成都生物製品研究所科研資料,1960.
10王良,馬明清.接種卡介苗後身體對其它疾病的抵抗力有無變動的實驗.1963年全國卡介苗經驗交流會資料.
11王良,馬明清.幾個菌株培養在不同培養基中pH變化的比較試驗.1963年全國卡介苗經驗交流會資料.
12王良,馬明清.沉降法測定卡介苗的細勻程度.1963年全國卡介苗經驗交流會資料.
13王良,馬明清.卡介苗免疫和結核菌感染後動物肝臟幾種酶活力變化的比較研究.衛生部成都生物製品研究所科研資料,1964.
14王良,王方枬,馬明清.巴西與丹麥卡介苗菌株接種動物的免疫力比較實驗.生物製品通訊,1964,5(2):139143.
15王良,馬明清,程鑫傅.分離卡介苗純菌種試驗.衛生部成都生物製品研究所科研資料,1965.
16衛生部成都生物製品研究所卡介苗室.卡介苗延長效期的試驗.衛生部成都生物製品研究所科研資料,1973.
17衛生部成都生物製品研究所第四研究室.兩年來測定卡介苗活菌數的概況.衛生部成都生物製品研究所科研資料,1973.
18王良,馬明清.現生產菌種(北京6442株)與丹麥1331株、日本172株的比較.1982年全國卡介苗經驗交流會資料.

